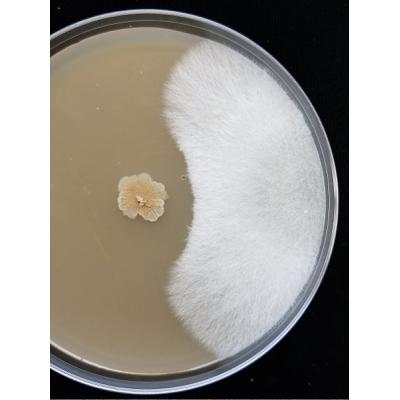
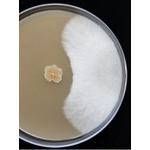

'Bacillus' is a word borrowed from Latin 'bacillus'. The word entered the English language some time around 1879.
bacillus [noun] [circa 1879]
- any of a genus B. anthracis (Bacillus) of rod-shaped gram-positive usually aerobic bacteria producing endospores and i...
- a straight rod-shaped bacterium
- bacterium
- a disease-producing bacterium
See 'bacillus' on the Loan Words Map
See more loan words from Latin.
Etymology: New Latin, from Medieval Latin, small staff, rod, diminutive of Latin 'baculus' staff, alteration of 'baculum'
See more loan words from 1800s.
No comments:
Post a Comment